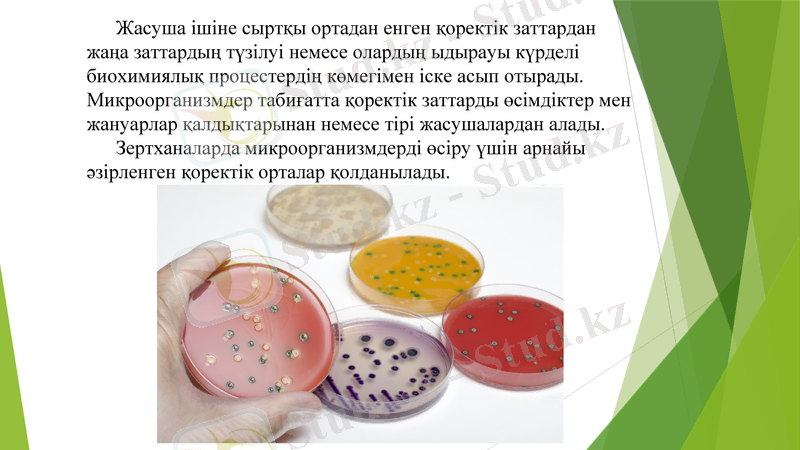
Slide 3
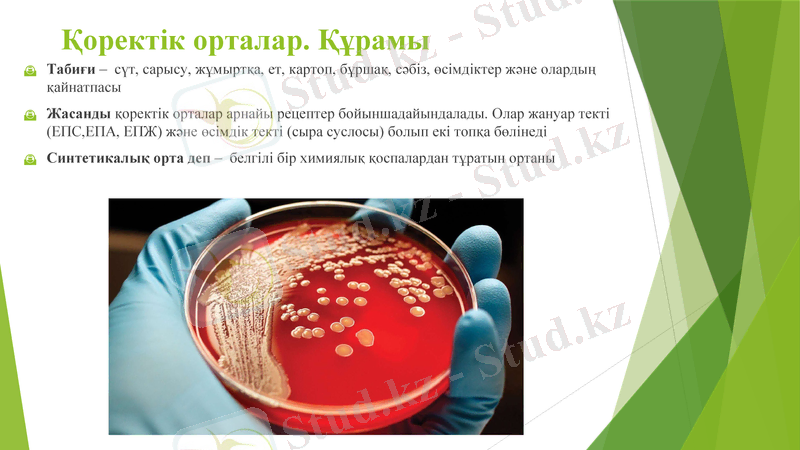
Slide 5
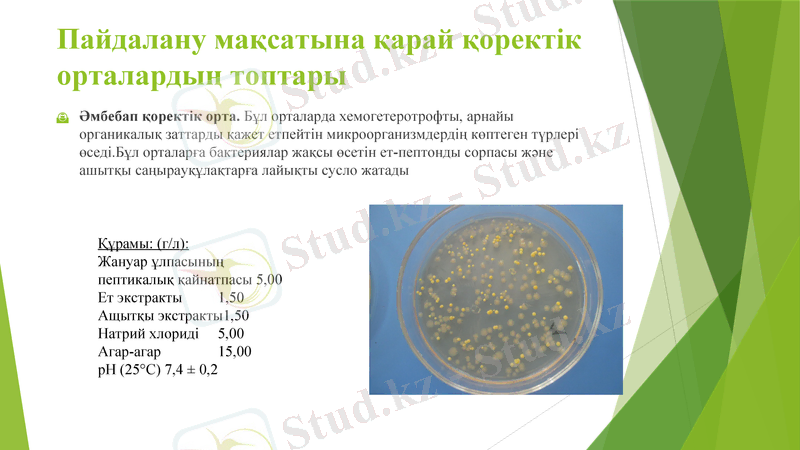
Slide 6
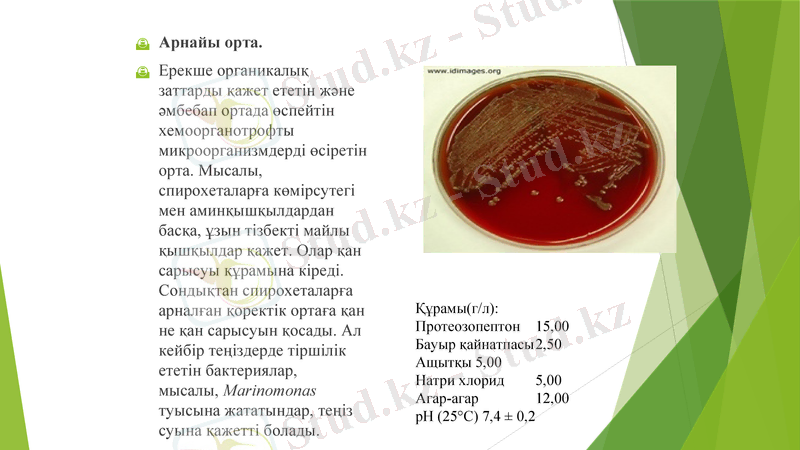
Slide 8

Микроорганизмдерді дақылдау: қоректік орталар, залалсыздандыру және аэробты/анаэробты әдістері



Микроорганизмдердің өсуі және дақылдау

Жоспары:
Микроорганизмдерді дақылдауға арналған қоректік орталар, қоректік орталардың залалсыздандыру әдістері.
Қоректік орталардың құрамы мен физикалық күйінің негізгі типтері.
Микроорганизмдерді дақылдау әдістері.
Аэробты және анаэробты микроорганизмдерді дақылдау.
Қорытынды.
Пайдаланылған әдебиеттер.
Жасуша ішіне сыртқы ортадан енген қоректік заттардан жаңа заттардың түзілуі немесе олардың ыдырауы күрделі биохимиялық процестердің көмегімен іске асып отырады. Микроорганизмдер табиғатта қоректік заттарды өсімдіктер мен жануарлар қалдықтарынан немесе тірі жасушалардан алады.
Зертханаларда микроорганизмдерді өсіру үшін арнайы әзірленген қоректік орталар қолданылады.

Микроорганимздерді дақылдауға арналған қоректік орта және олардың түрлері :
Қоректік орталар. Құрамы
Табиғи - сүт, сарысу, жұмыртқа, ет, картоп, бұршақ, сәбіз, өсімдіктер және олардың қайнатпасы
Жасанды қоректік орталар арнайы рецептер бойыншадайындалады. Олар жануар текті (ЕПС, ЕПА, ЕПЖ) және өсімдік текті (сыра суслосы) болып екі топқа бөлінеді
Синтетикалық орта деп - белгілі бір химиялық қоспалардан тұратын ортаны
Пайдалану мақсатына қарай қоректік орталардың топтары
Әмбебап қоректік орта. Бұл орталарда хемогетеротрофты, арнайы органикалық заттарды қажет етпейтін микроорганизмдердің көптеген түрлері өседі. Бұл орталарға бактериялар жақсы өсетін ет-пептонды сорпасы және ашытқы саңырауқұлақтарға лайықты сусло жатады
Құрамы: (г/л) :
Жануар ұлпасының пептикалық қайнатпасы 5, 00
Ет экстракты 1, 50
Ащытқы экстракты1, 50
Натрий хлориді 5, 00
Агар-агар 15, 00
рН (25°С) 7, 4 ± 0, 2

Мюллера-Хинтонның Әмбебап қоректік ортасы
Neisseria sp үшін қолданады
және
Микроағзалардың антибиотикке сезімталдығын анықтайды.
Құрамы (г/л) :
Ет 300, 00
Казеина гидролизаты 17, 50
Крахмал 1, 50
Агар-агар 17, 00
рН ( 25°С) 7, 3 ± 0, 2
Арнайы орта.
Ерекше органикалық заттарды қажет ететін және әмбебап ортада өспейтін хемоорганотрофты микроорганизмдерді өсіретін орта. Мысалы, спирохеталарға көмірсутегі мен аминқышқылдардан басқа, ұзын тізбекті майлы қышқылдар қажет. Олар қан сарысуы құрамына кіреді. Сондықтан спирохеталарға арналған қоректік ортаға қан не қан сарысуын қосады. Ал кейбір теңіздерде тіршілік ететін бактериялар, мысалы, Marinomonas туысына жататындар, теңіз суына қажетті болады.
Құрамы(г/л) :
Протеозопептон 15, 00
Бауыр қайнатпасы 2, 50
Ащытқы 5, 00
Натри хлорид 5, 00
Агар-агар 12, 00
рН (25°С) 7, 4 ± 0, 2

Элективті немесе таңдамалы орта.
Бұл орта табиғи субстраттардан (топырақ, су, тағамдардан, өсімдік пен жануарлардан) микроорганизмдердің жеке топтарын бөліп алуға арналған. Оларды микробиологияға С. И. Виноградский енгізді. Элективті деп микроорганизмдердің белгілі бір тобының немесе түрінің өсуіне қажетті құрамы ерекше қоректік орталарды атайды.
9
Құрамы (г/л) :
Арнайы пептон 2, 50
Ет 2, 50
Натрий хлориді 1, 25
Глюкоза 2, 50
рН ( 25°С) 7, 3 ± 0, 2

Дифференциалды-диагностикалық орталар. Бұл орталарды жалпы микробиологияда әр түрлі субстраттардан бөліп алынған бактериялардың физиологиялық-биохимиялық қасиеттерін анықтап, оларды жіктеу үшін пайдаланады. Ал медициналық және ветеринарлық микробиологияда оларды ауруларды қоздыратын бактерияларды анықтау үшін қолданады. Бұл орталар бактериялардың белгілі бір ферменттерінің, мысалы, каталаза, оксидаза, протеаза, фосфотаза, желатиназа және гемолитикалық ферменттердің бар-жоғын анықтау үшін қажет.
10
Левин ортасы
Плоскирев ортасы
Гисс қоректік ортасы

Ет-пептонды сорпа (ЕПС) . Ет суына 1% пептон мен 0, 5% натрий хлоридын қосады. Ет суын пептонның толық ерігеніне дейін араластыра отыра қайнатып, оның рН мөлшерін потенциометрдің көмегімен анықтайды. Қоректікортаның рН-ын 10% натрий сілтісінің ерітіндісі немесе натрий гидрокарбонатынң (ас содасының) қаныққан ерітіндісімен 7, 4-7, 6-ға жеткізеді. Сілтіні сорпаға қосқаннан кейін, оны тағы да 5-10 минут қайнатады. Сонан соң сорпаны дистильденген сумен дымқылданған сүзгіш қағаздан өткізеді. Ет-пептонды сорпаны шыны түтіктерге құйып 1200С-та 20-30 минут стерильдейді.
11

Қоректік орталарға қойылатын шарттар:

Роберт Кох Қоректік сорпаны тығыз массаға айналдыру үшін желатинді қолдануды ұсынды. .
Кемшілігі: 25 С температурада балқиды
Вальтер Хессе (1846 - 1911)
В. Хессе қоректік ортаның тығыз болуына агар-агарады қолдануды ұсынды
Роберт Кох (1843-1910)
13

Қоректік орталарды залалсыздандыру
Микроорганизмдерді өсіруге арналған қоректік орталарда басқа микроорганизмдердің тірі клеткалары және олардың споралары мүлде болмауы керек. Бөгде микроорганизмдерді жою үшін арнайы залалсыздандыру әдістерін қолданады. Бұл мақсатта, көбінесе, жоғары температураның әсерін пайдаланады. Температура микробтардың өсуіне лайықты деңгейінен жоғарылаған сайын, оның әсері күшейе түсетіндігі бұрыннан белгілі. Температураның әсерін микроорганизмдер популяциясының белгілі бір бөлігін жою үшін қажетті уақытпен сипаттайды.

Микроорганизмдерді дақылдау әдістері:
1. Беттік дақылдау деп аэробты микроорганизмдерді сұйық және сусымалы орталардың бетінде өсіруді айтамыз. Бұнда микроорганизмдер оттегіні тікелей ауадан алады. Беттік дақылдау әдісінің кемшілігі мен артықшылығы болады. Кемшілігі: үлкен аймақты қажет ететіндігі; Артықшылығы: соңғы өнім концентрациясының жоғары болуы.
2. Түптік дақылдау - микроорганизмдер қоректік ортаның барлық көлемінде дами алатын сұйық қоректік орталарда жүргізіледі. Ол арнайы аппаратта фэробты микроорганизмдердің өсуін қамтамасыз ету үшін арнайы ферментаторда жүзеге асырылады.
3. Мерзімді дақылдау кезінде қоректік ортаның барлық көлемін таза культурамен егіп тастайды, ол қолайлы жағдайда, белгілі уақыт аралығында, керекті өнімнің мөлшерін жинағанша өсіріледі.
4. Ағынды режимде культураларды өсіру әдісі үздіксіз дақылдау деп аталады. Ағынды жүйені құру негізіндегі тәжірибелерде культураның экспоненциалдық өсу фазасында жаңа қоректік орта бөлігін супензияға қосу клеткалардың бөлінуін ұзақ қолдайды. Үздіксіз дақылдау жабық ағынды және ашық ағынды жүйелермен іске асады.

Үздіксіз дақылдау, экспоненциалды даму фазасында микроорганизмдердің тіршілік етуін ұстап тұру үшін ферменттерге белгілі мөлшерде сандық және сапалық қатынастарда қоректік заттарды үздіксіз беріп отыру болып табылады. Мұндай жағдайларға қозғалмалы күйден тепе - тең күйге жеткізеді, бұл кезде жасушалардың үздіксіз жағдайда және бірден жылдамдықпен көбеюі, қоректік заттардың келіп түсу жылдамдығымен сәйкес келеді.

Анаэробтарды дақылдандыру тәсілдері:
• Жартылай сұйық ағар құйылған пробиркаға жоғарыдан түбіне дейін себу әдісімен.
• Анаэростатта өсіру - саңылауы жоқ жабық ыдыстарда:
- механикалық әдіс бойынша ауаны, вакуумдық насос арқылы шығару;
- химиялық әдіс «пирогаллолмен», «ГазПак»;
- ауаның инертті газбен (азот) алмасуы немесе оттексіз газдың қоспасымен (N2-85%, CO2-10%, H2-5%) .
• Биологиялық (Фортнер әдісі) - аэроб пен анаэробтарды бірге өсіру.
• Веньяль-Вейон әдісі - қантты агары бар пробиркаға пипеткамен балқытылған агарға себу.
- Іс жүргізу
- Автоматтандыру, Техника
- Алғашқы әскери дайындық
- Астрономия
- Ауыл шаруашылығы
- Банк ісі
- Бизнесті бағалау
- Биология
- Бухгалтерлік іс
- Валеология
- Ветеринария
- География
- Геология, Геофизика, Геодезия
- Дін
- Ет, сүт, шарап өнімдері
- Жалпы тарих
- Жер кадастрі, Жылжымайтын мүлік
- Журналистика
- Информатика
- Кеден ісі
- Маркетинг
- Математика, Геометрия
- Медицина
- Мемлекеттік басқару
- Менеджмент
- Мұнай, Газ
- Мұрағат ісі
- Мәдениеттану
- ОБЖ (Основы безопасности жизнедеятельности)
- Педагогика
- Полиграфия
- Психология
- Салық
- Саясаттану
- Сақтандыру
- Сертификаттау, стандарттау
- Социология, Демография
- Спорт
- Статистика
- Тілтану, Филология
- Тарихи тұлғалар
- Тау-кен ісі
- Транспорт
- Туризм
- Физика
- Философия
- Халықаралық қатынастар
- Химия
- Экология, Қоршаған ортаны қорғау
- Экономика
- Экономикалық география
- Электротехника
- Қазақстан тарихы
- Қаржы
- Құрылыс
- Құқық, Криминалистика
- Әдебиет
- Өнер, музыка
- Өнеркәсіп, Өндіріс
Қазақ тілінде жазылған рефераттар, курстық жұмыстар, дипломдық жұмыстар бойынша біздің қор #1 болып табылады.



Ақпарат
Қосымша
Email: info@stud.kz